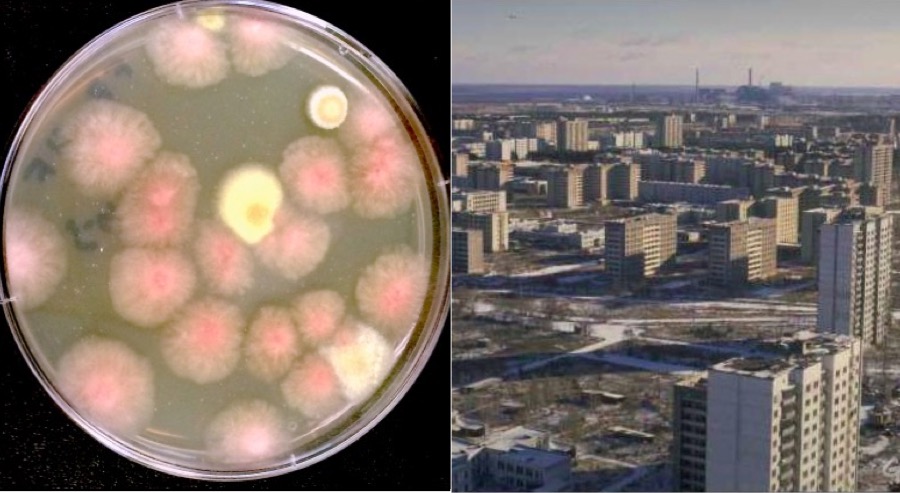

L’accident de Tchernobyl qui s’est déroulé il y a une trentaine d’années est sans doute une des plus graves catastrophes causées par l’être humain. Cependant, la NASA estime que cet événement tragique pourrait fournir une aide précieuse pour coloniser la planète rouge.
Afin de comprendre ce qui intéresse la NASA, il est essentiel de rappeler la catastrophe de 1986. Les ingénieurs de la centrale nucléaire ont mené un exercice destiné à prouver que les réacteurs étaient capables de se relancer par eux-mêmes en cas de coupure de courant. Cependant, l’échec a été total puisqu’un des réacteurs est devenu instable et a commencé à produire du Xénon et de l’Iode en grande quantité.
La situation est ensuite devenue critique dès lors qu’une explosion s’est produite au niveau du réacteur N° 4. Le gaz s’est échappé dans l’air après la fonte de la gaine des crayons d’uranium et a formé un immense nuage qui s’est baladé autour du globe durant des années. Un dôme de confinement a ensuite été mis en place pour contenir la catastrophe, mais le mal était déjà fait. Cette mégastructure n’a pas empêché la radioactivité de s’installer durablement dans la région à des taux astronomiques.
Durant ces dernières années, la zone autour de Tchernobyl est étudiée par des scientifiques en ce qui concerne précisément l’impact immédiat (et sur le long terme) de la radioactivité sur la faune et la flore. La NASA s’intéresse donc à ces recherches dont le but est de comprendre comment les organismes vivants peuvent s’adapter à de très importantes doses de radiation.
Nous savons que la NASA prépare depuis quelques années la colonisation de la planète Mars en y établissant une base. Cependant, cette mission s’avère périlleuse pour plusieurs raisons. Bien sûr, Mars n’est pas respirable, mais il y a pire : celle-ci ne possède aucun champ magnétique global, c’est-à-dire aucune protection contre les rayonnements cosmiques et solaires. Les seules solutions étudiées pour l’instant sont de bâtir des dômes protecteurs ou d’établir une base sous la surface.
La NASA désire se lancer sur une nouvelle piste en étudiant l’impact direct des radiations sur les organismes vivants et c’est pour cette raison que huit espèces de champignons provenant de la zone infectée ont été envoyées sur la Station spatiale internationale (ISS) en 2016 (voir ci-dessous).

Kasthuri Venkateswaran, chercheur pour le Jet Propulsion Laboratory de la NASA, évoque aujourd’hui une découverte intéressante : les champignons ont développé une résistance aux radiations en synthétisant une biomolécule.
L’intéressé explique pour MotherBoard : « Les radiations observées à Tchernobyl sont élevées, mais ces champignons sont apparus en premier [après l’accident], avant même les bactéries. C’est pour ça que nous les avons choisis dans un environnement aussi irradié. Ces champignons ont survécu grâce à des protéines et des informations biomoléculaires qui les protègent des radiations. »
L’expert pense que cette particularité pourrait être reproduite dans un laboratoire et entrer dans la fabrication d’une crème ayant pour but de protéger les hommes face aux rayons auxquels ces derniers seront exposés dans l’espace. Les scientifiques portent de l’intérêt à Tchernobyl également en ce qui concerne la végétation présente dans la zone. Il s’agit de mieux comprendre leurs dispositions et peut-être créer des cultures plus résistantes pouvant s’adapter à la vie martienne.
Sources : MotherBoard – FredZone